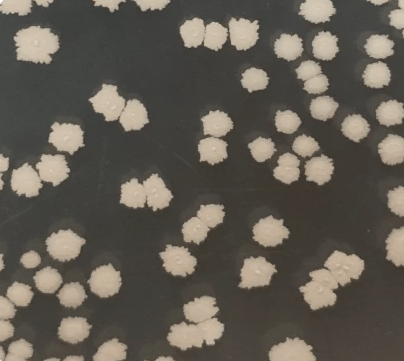
Section image

貝萊斯寶
貝萊斯芽孢桿菌BACY
最新消息

股務提醒:小心詐騙
近年來常有股東接到電話詐騙股票事宜,請勿相信

Bacillus subtilis Y1336 列入2021 FRAC List
2021年03月公告的FRAC List(殺菌劑抗藥性行動委員會-殺菌劑清單),百泰的台灣寶™ BIOBAC --Bacillus subtilis Y1336 (以下簡稱Y1336)產品 已經被列入清單之中,與世界國際大廠Bayer、 BASF、 Sygenta等產品並列。顯見百泰的Y1336已經在國際上有一定的知名度與市場佔有率,暨Y1336產品的穩定品質、作物病害防治效果,受到全球認同肯定。而且Y1336目前已取得15國以上的生物農藥登記證與生物肥料登記證。我們很榮幸也很高興地與各位分享以上的訊息,百泰的旗艦產品--台灣寶™ BIOBAC已經在國際的生物殺菌劑市場中佔有一席非常重要的地位。

創辦人陳良榮先生卸任中華農藥協會理事長卸任感言
(2021年11月2日)
本公司及創辦人共同聲明
(2020年10月27日)不實報導侵害商譽、名譽 鑑驗結果還清白

日本溫室風管施用
枯草芽孢桿菌Y1336取得日本溫室風管施用產品註冊

2019.01.14
百泰生物科技創辦人當選第八屆中華農藥協會理事長

2017.07.27
百泰生物農藥枯草芽孢桿菌Y1336喜獲中國
植保產品貢獻獎

2016.06.10
百泰生技發明展正式簽約授權

2016.09.29
百泰火山挖寶謢食安 交易展成焦點

2016.01.14
百泰創辦人 陳良榮 專訪